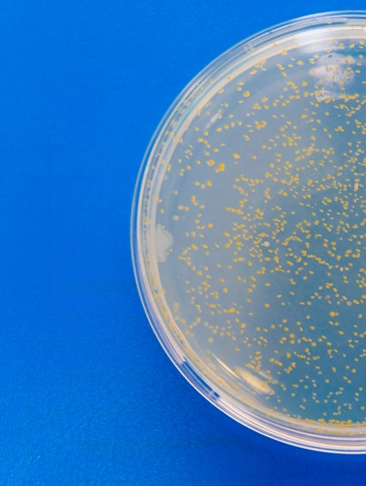
colony
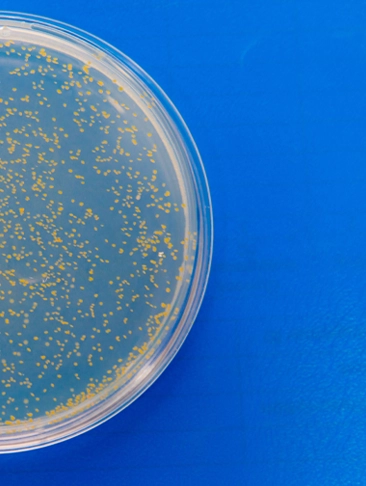
colony

Backed by comprehensive professional licensing and advanced environmental testing certifications, we provide science-driven assessments designed for accuracy, safety, and regulatory compliance. Our specialized services, covering potable and non-potable water, mold, Legionella, and onsite sampling, are performed by qualified experts committed to high-quality results.
Explore our credentials on the Certifications & Accreditations page.
Take action today, your building’s safety starts with a reliable assessment.
"*" indicates required fields
By combining advanced methodologies, regulatory expertise, and a customer-first approach, we empower businesses and property owners to meet safety and compliance goals effortlessly. Whether protecting health, preserving resources, or mitigating risks, we’re here to provide the assurance you need for a cleaner, safer future.
We maintain the highest standards in environmental compliance and sustainability. Our certifications demonstrate our commitment to responsible practices and regulatory excellence.
Protect your environment with our specialized water and air quality testing solutions, offering comprehensive analysis to detect contaminants, convenient sample collection, and on-site testing for immediate results. Contact us today to schedule a consultation or on-site visit and take the first step toward a healthier, safer environment!
Homeowners, businesses, and property managers often face challenges ensuring water safety but lack the time or expertise to manage testing. That’s where we step in.
Our professional team offers comprehensive water testing services tailored to your needs, including potable water testing for drinking water systems, non-potable water testing for wastewater and runoff, detailed mold assessment, and Legionella risk assessment for cooling towers and healthcare facilities.
Each of our services is backed by certified sampling services and accurate lab analysis to help you meet local, state, and federal guidelines.
We stay up-to-date with evolving regulations, whether you need to meet EPA guidelines, state mandates, or regulatory compliance requirements for Legionella and wastewater discharge.
Our team of certified professionals has extensive experience in environmental testing, delivering accurate and reliable results.
With timely and thorough testing services, you can focus on your business while we handle your environmental safety concerns.
Our expert team empowers clients to achieve outstanding results by delivering accurate, reliable, and timely environmental analyses. With a steadfast focus on quality and efficiency, we strive to be your trusted partner in achieving compliance, safeguarding public health, and protecting the environment.
Explore our locations served to see how we support compliance across New York, New Jersey, and beyond.

We offer both testing and onsite sampling services. Our team can visit your location to collect water, air, or surface samples to ensure proper handling and accurate results. This service is especially useful for clients who need professional support in sampling or have complex testing needs.
We serve customers in New Jersey, New York, and surrounding regions. Contact us to confirm if we provide services in your specific location.
You can schedule a test or consultation by contacting us via phone, email, or our online booking form. Our team will guide you through the process and recommend the best services for your needs.
We offer comprehensive private well testing, including bacteria (E. coli, Total Coliform), heavy metals (lead, arsenic), nitrates, nitrites, and other contaminants. These tests ensure your water is safe for consumption and meets local and federal safety standards.
Yes, we specialize in Legionella testing for residential, commercial, and industrial water systems, including cooling towers, potable water, and HVAC systems, ensuring compliance with regulations like ASHRAE 188 and CDC guidelines.
Don’t see your answer here? Our support team is ready to assist you with any specific concerns or detailed inquiries.
Fill out the form below, and our team will get back to you as soon as possible.
"*" indicates required fields